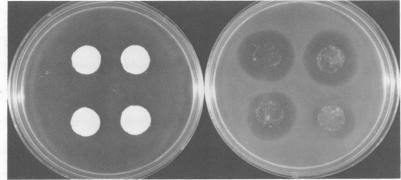
https://cdn.ncbi.nlm.nih.gov/pmc/blobs/6404/291518/7283cfce6aca/aem00237-0023-a.jpg

Rapid detection of staphylococcal thermonuclease on casings of naturally contaminated fermented sausages.
作者信息
Emswiler-Rose B S, Johnston R W, Harris M E, Lee W H
出版信息
Appl Environ Microbiol. 1980 Jul;40(1):13-8. doi: 10.1128/aem.40.1.13-18.1980.
Staphylococcal food poisoning associated with fermented sausages has been a recurring problem. By testing for thermonuclease by direct application of sausage casing disks on the surface of thermonuclease assay agar plates, possible Staphylococcus aureus growth in fermented sausages could be detected simply and rapidly. Koupal-Deibel deoxyribonucleic acid agar was somewhat superior to toluidine blue deoxyribonucleic acid agar for thermonuclease assay of fermented sausage casings. The sensitivity of the thermonuclease casing test was comparable to that of the extraction procedure, and the thermonuclease casing test results were in complete agreement with the thermonuclease assay results by the extraction procedure. The thermonuclease casing test offers government and industry laboratories a useful screening tool which could significantly reduce the problem of staphylococcal enterotoxins in fermented sausages.